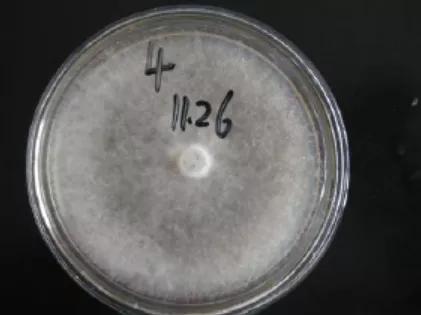
水产养殖霉菌怎么处理,水产养殖杀水霉方法

揭示水霉菌繁殖和侵染过程
水霉病又称为肤霉病、白毛病,是淡水养殖动物常见致病菌。水霉(Saprolegnia)隶属于茸鞭生物界(Stramenopila)、鞭毛菌亚门(Mastigomycotina)、卵菌纲(Oomycetes)、水霉目(Saprolegniales)、水霉科(Sprolegniaceae),主要包括水霉属(Saprolegnia)、绵霉属(Achlya)、丝囊菌属(Aphanomyces)等。水霉病常年发生,尤其是在冬春两季。水霉病的发生主要是水霉孢子大量繁殖、鱼体表受伤或免疫力下降和温度骤变等原因共同造成(Behrens等,1994;Khulbe等,1995)。
水霉繁殖包括有性繁殖和无性繁殖,其中无性繁殖最为常见。水霉的无性繁殖是指在适当环境条件下,水霉菌丝发育为游动孢子囊,游动孢子囊内形成游动孢子,游动孢子囊顶端形成小孔,具有两根顶生鞭毛的梨形孢子(第一型游动孢子)逸出,经过短期游动后,进入静止期,后在静体上形成一个具有两根侧生鞭毛的肾形孢子(第二型游动孢子),再经过短时间游动后就休止,休止孢子萌发成芽管,芽管发育成新的菌丝。

图1 水霉无性繁殖(引自Hughes,1994;)
A:菌丝;B:孢子囊;C:游动孢子释放;D初生游动孢子(第一型游动孢子);E-F:初生孢孢子(静止);G:释放次生游动孢子;H:次生游动孢子(第二型游动孢子);I:次生孢孢子;J:孢子萌发。
水霉的有性繁殖 是在条件有利有性生殖时,营养菌丝上形成较大的球状藏卵器和较小的菌丝状雄器。藏卵器球形或梨形,多数顶生,少数侧生。藏卵器具有雄性器官,雄器短而粗与藏卵器同枝,少数异枝。减数分裂则在配子囊内发生,雄器通过受精管穿过藏卵器壁到达卵球,进行质配和核配。
受精后形成卵孢子,卵孢子分化呈中央型或亚中央型,每个藏卵器3~25个卵孢子不等,卵孢子由藏卵器壁的分解而释出,经过3~4个月休眠后萌发产生具有短柄的游动孢子囊或菌丝,完成整个生活史。


图2 水霉有性生殖(引自夏文伟,2011)
A:藏卵器与雄器异枝;B: 藏卵器与雄器同枝
本实验以水霉菌标准菌株为研究对象,通过对水霉菌落形态和繁殖过程的显微镜观察,从而了解水霉菌的生长形态,水霉菌的生长繁殖过程,水霉菌孢子释放过程等,为鉴定和预防水霉病提供参考依据。
1 .材料和方法
1.1 实验材料
供试菌株:致病性水霉菌保存于武汉华扬动物保健集团技术中心。实验试剂:PDA(Potato Dextrose Agar)培养基(青岛高科技工业园海博生物技术有限公司)。实验仪器:恒温培养箱,光学显微镜,电子天平,高压蒸汽灭菌锅等。
1.2 实验方法
将保种的水霉菌涂布于PDA培养基,28℃恒温培养。待长出单菌落后,将单菌落接种至50ml PDA液体培养基,28℃摇床培养4-5d,制备水霉菌液,制片并在显微镜下观察。将300ul水霉菌液涂布PDA平板,28℃恒温培养4-5d,持续观察水霉菌落形态,待水霉菌丝长满整个平板后,加入10ml无菌水并轻刮表面,使水霉孢子充分融入无菌水中。将混有水霉孢子无菌水至离心管中,3000rpm离心5min,除去菌丝等杂质。制备水霉孢子液制片并显微观察。
2 .实验结果与分析
2.1 水霉菌落结果与分析
通过对水霉菌落持续观察,结果显示,水霉菌在PDA培养基培养24h时,同一平板不同单菌落生长快慢有差异。初始水霉菌落形态无规则,颜色较浅(图3A)。培养48 h,水霉菌落呈放射状生长,菌落为规则的圆形,边缘整齐,菌丝深入到琼脂内部,交织成网状,生长在琼脂外部为灰白色絮状物(图3B)。之后继续培养,菌丝长满整个培养基(图3C)。实验结果对水霉病防控具有一定指导意义,水霉病重在预防,一旦水霉病爆发,菌丝向内生长,会深入肌肉很难杀灭。提前预防,可以将水霉菌丝和水霉孢子杀灭在水体中,避免通过伤口感染鱼体。



图3 水霉菌落形态
A:24h水霉菌落形态;B:48h水霉菌落形态;C:72h水霉菌落形态.该实验观察菌落形态与图4相似(夏文伟,2011;粱永增2016)。

图4 水霉菌落形态(引自夏文伟,2011;粱永增,2016)
2.2 水霉显微镜结果与分析
水霉孢子液和水霉菌液制片在显微镜下观察结果如图5,结果显示,孢子多为游动,形状为近似圆形。水霉孢子游动,也导致了水霉病传染迅速。因此,水霉病一定要早发现早治疗。待看到鱼体表有白毛时,会释放更多的水霉孢子到水体中,加重水霉的感染。

① A

② B

① C

② D
图5水霉孢子
A:水霉孢子液孢子(40 x);B: 水霉孢子液孢子(100x);C:水霉菌液孢子(40 x);B: 水霉菌液孢子(100 x)
该实验观察水霉孢子形态与图6相似(刘荣军,2014;韩灵莉;2017)。


图6 水霉孢子(引自刘荣军,2014;韩灵莉;2017)
水霉菌液显微结果显示,水霉菌丝为透明管状结构,中间无横隔,分支较少,细长。顶端为游动孢子囊,且多呈棒状(图7)。


图7 水霉菌丝与孢子囊(40x)
该实验观察水霉菌丝与孢子囊形态与图8相似(许佳露, 2012)。

图8 水霉菌丝与孢子囊(引自许佳露,2012)
孢子囊中有游动孢子,游动孢子呈多排排列,发育成熟后从孢子囊顶端释放出来,并迅速游离(图9)。水霉病的防控需要注意,一旦看到长白毛的病鱼,及时捞出,避免菌丝末端孢子囊释放孢子到水体中感染更多的鱼。



图9水霉孢子囊释放孢子(100x)
该实验观察水霉孢子囊释放孢子过程与图10相似(Ke等,2009;许佳露,2012;夏文伟,2011)。



图10水霉孢子囊释放孢子(引自Ke等,2009;许佳露,2012;夏文伟,2011)

图11 新游动孢子囊以内层出方式产生(40x)
该实验观察水霉新游动孢子囊以内层出方式产生与图12相似(许佳露,2012;Ke等,2009;张楠,2014)。



图12 新游动孢子囊以内层出方式产生(引自许佳露,2012;Ke等,2009;张楠,2014)
3. 讨论
本文揭示了水霉菌的繁殖过程是菌丝大量生长后,在菌丝的末端长出孢子囊,孢子囊一定程度后会从顶端释放孢子,游动孢子在水体和鱼体遇到合适机会会萌发生长,长出新的菌丝继续繁殖。水霉病的发生过程可以是孢子侵染伤口或菌丝粘附伤口,导致水霉菌大量繁殖引起发病。水霉病的防控一定要注意的是,用能杀灭游动孢子的产品提前杀灭孢子,避免鱼体表面的菌丝末端孢子囊释放更多游动孢子。
水霉菌是水产动物重要致病菌,感染的水产动物体表覆盖白色絮状物菌丝,同时伴随食欲不振,躁动不安和免疫下降。水霉孢子大量繁殖可引起水产动物水霉病爆发。本研究水霉菌落形态结果显示,水霉在PDA培养基上形成的菌落呈放射状,菌落为规则的圆形,边缘整齐,菌丝深入到琼脂内部,交织成网状,生长在琼脂外部份,为灰白色絮状物;水霉显微镜观察结果显示,水霉菌丝为透明管状结构,顶端为游动孢子囊,孢子囊中有游动孢子,发育成熟后从孢子囊顶端释放出来,并迅速游离,孢子从孢子囊释放后,孢子囊前端成为空囊,新游动孢子囊会以内层扩散方式重新形成。
水霉病的发生特点?水霉发生温度范围广,水霉孢子在自然环境大量存在,对环境耐受性极强,对温度适应范围很广;水霉发生主要受温度影响,当水温低于20℃时水霉病原菌适宜繁殖,其最适繁殖温度为10-18℃,水霉菌在15℃左右时生长最活跃,水温高于28℃才能抑制水霉孢子繁殖。因此,水霉病并不是只有冬季低温期发生,水温低于20℃都要预防该病的发生;水霉发生的后期,水霉菌菌丝着生在水体表伤口后,菌丝会深入肌肉,很难杀灭,因此水霉病主要靠预防。在水霉适宜繁殖的季节(水温低于20℃)提前使用药物将水霉孢子杀灭在水体中(如华扬君美净);水霉菌感染对象多,水霉病是由水霉菌引起的真菌性疾病,对水生动物种类没有选择性,凡受伤的机体和卵均可被感染致病。
如何有效防控水霉病?(1)选择有效防治水霉病的药物很关键。防治水霉病的药物有很多种,如何选择有效药物直接决定了防治效果。防治水霉病的药物可以分为抑菌型的主要用于预防,如硫醚沙星等,主要是抑制水霉菌的生长,一旦观察到白毛菌丝,如果不能杀菌是没有治疗效果的;有去除菌丝性和恢复伤口型的,如五倍子、水杨酸等,主要用于脱落菌丝和收敛伤口,不能杀灭水霉,也起不到治疗效果;一种是治疗型的,具有杀菌效果,可以杀灭水霉菌,具有真正的治疗效果。华扬君美净融合了五倍子提取物收敛伤口和抑杀水霉菌的双重效果具有很好的防治水霉病效果。(2)秋冬捕鱼时,避免和减少鱼体受伤。(3)及时杀灭水体和鱼体体表寄生虫,减少寄生虫造成伤口和病菌传播。(4)越冬前提前内服应激宁等中药类产品,提升鱼体体质,增氧机体免疫力。(5)在水霉适宜繁殖季节(水温10-18℃)提前使用可抑杀水霉孢子的产品,将水霉孢子抑杀在水体中。
4 参考文献
[1] Behrens P W, Sicotte V J, Delent s J. Microalgae as asource of stable iso topically labeled compounds.Journal of Applied Phycology, 1994, 6 (2): 113- 121.
[2] Ke X, Wang J, Gu Z, et al. Saprolegnia brachydanis, A New Oomycete Isolated from Zebra Fish[J]. Mycopathologia, 2009, 167(2):107-13.
[3] Khulbe R D, Bisht G S, Chandra J. An ecologicalstudy on watermolds of some rivers of Kumaun H imalaya. Journal of the Indian Bo tanical Society, 1995, 74 (3): 61- 64.
[4] Seymour R L. The genus Saprolegnia. Nova Hedwigia, 1970, 19: 1-124.
[5] 韩灵莉. 七彩神仙鱼水霉病的鉴定及其防治方法的研究[D]. 上海海洋大学. 2017.
[6] 梁永增. 鱼类水霉病病原生物拮抗菌的筛选及其拮抗机理分析[D]. *疆新**大学. 2016.
[7] 刘荣军. 30种中草药提取物对多子水霉体外抑制作用研究及厚朴抗水霉活性成分初步分析[D]. 四川农业大学. 2014.
[8] 夏文伟. 鲫卵源致病性水霉的分离与鉴定及其生物学特性研究[D]. 上海海洋大学. 2011.
[9] 许佳露.鱼类水霉病疾病模型的构建及应用[D]. 上海海洋大学. 2012.
[10] 张楠. 中国主要致病性水霉菌病原及水霉病暴发预警研究[D]. 上海海洋大学. 2014.